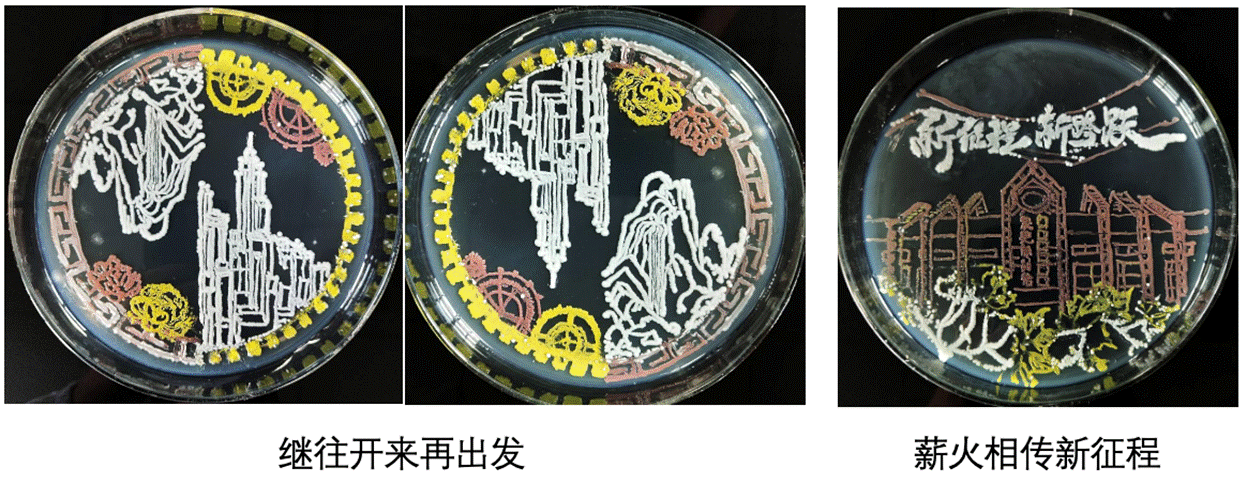

2023年12月4日,湖北省第二届微生物培养皿艺术设计大赛获奖名单出炉。公司获三等奖1项、优秀奖3项,公司教师白云、解晓慢获评优秀指导教师。公司积极组织,共向大赛组委会提交39组作品,助力必威西汉姆联官网再次获评优秀组织单位。
湖北省第二届微生物培养皿艺术设计大赛的主题为“科学探索‘微’之美,青春启航新征程”。自今年7月大赛启动以来,必威西汉姆联官网实验教学中心积极动员师生参与,提供专用实验场地及实验材料。9月5日,组织专场培训,讲解参赛流程、实验操作及注意事项,邀请往届获奖队伍分享微生物艺术创作经验,加深参赛同学对微生物作画的了解,使的备赛方向更加清晰。

在指导教师的精心指导下,参赛员工利用所学微生物基础知识,围绕大赛主题,发挥创新精神,不断提高实验技术操作水平和提升生命之美艺术涵养,完成参赛作品。
各参赛小组成员根据自己的创意,分别选用红色和白色的酵母菌、黄色的嗜根考克氏菌以及灰白色的大肠杆菌等彩色菌种进行实验。通过探索微生物最适生长条件,如培养基成分及比例、培养温度、培养湿度、培养时间等,以及不同作画工具、不同菌液浓度对绘画结果的影响,确定最佳实验方案,最终呈现丰富多彩的微生物画作品。
获奖作品展示如下:
三等奖(1项)
作品名称:花young(漾)
参赛员工:何雨芮 尹荔芝
指导教师:解晓慢 白云

优秀奖(3项)
作品名称:《月色(图一:月光倾泻如瀑;图二:明月别枝惊鹊)》
参赛员工:李忆欣 胡可馨
指导教师:白虹

作品名称:《继往开来再出发 薪火相传新征程》
参赛员工:李玉娇 李婧榕 孙天骄
指导教师:曾小美
作品名称:《翻云腾龙》
参赛员工:盘飞燕 李昕怡 张嘉仪
指导教师:白虹 曾小美

必威西汉姆联官网将继续发挥科普基地育人优势,通过举办和组织员工参加各类科普创意竞赛,充分给予员工动手实践机会,在提升员工实验操作能力的同时,不断增强员工对“生命之美”的艺术鉴赏力和创造力,多维度激发员工钻研生命科学的志趣。